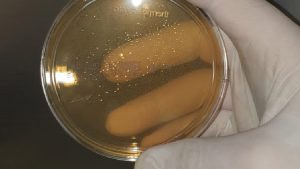

Kostenlose Bilder / Fotos für jedermann zum Thema Reinigung
Gute Bilder und Fotos kann man immer gebrauchen, aber die Beschaffung ist nicht immer einfach. Selber hat man meist keine professionelle Kamera, nicht die Zeit für schöne Aufnahmen, … Da ist es natürlich einfacher sich irgendwo einfach zu bediehnen, was aber strafbar und mit Risiko verbunden ist. Abmahnungen sind teuer. Besser man sucht sich gleich kostenlose Bilder aus, welche man bedenkenlos verwenden kann. Das Unternehmen SRG GmbH aus Hannover möchte Ihnen zumindest im eigenen Themenberecht mit solchen Bildern / Fotos weiterhelfen, da man hier sozusagen aufgrund der beruflichen Tätigkeit direkt an der Quelle sitzt. Ob Glasreinigung, Gebäudereinigung, Reinigung von Böden, Verschmutzung oder Vorher / Nachher Bilder, vielleicht finden Sie ja hier das passende Gratisbild für die eigene Homepage, Reportage, Blogartikel, …
Wie „honoriert“ man Gratisbilder und unsere Arbeit ?
Professionelle Bilder sind nicht einfach zu erstellen, man benötigt Equipment, Geld und Zeit zum Zuschnitt, Bildbearbeitung, Einstellung auf die eigene Homepage, usw. Wenn Sie für ein benötigtes Bild eine Agentur beauftragen würden, dann würde das sehr sehr viel Geld kosten. Wir möchten kein Geld, aber bitte vergessen Sie nicht bei einer Verwendung eine Quellenangabe in Form eines Links zu uns zu setzen. Vielen Dank.
Unsere Bilddatenbank wächst ständig.
Es lohnt sich immer mal wieder vorbeizuschauen, denn die Anzahl der kostenlosen Bilder / Fotos wird permanent ansteigen. Ein Fotoapparat ist während der Arbeit unser ständiger Begleiter. Vielleicht ist ja jetzt bereits das passende Gratisbild mit dabei, ansonsten schauen Sie zu einem späteren Zeitpunkt wieder vorbei.
HINWEIS: Falls Sie ein Reinigungsprojekt in Hannover, der Umgebung oder ganz Deutschland zu vergeben haben, würden wir uns ebenfalls über eine Kontaktaufnahme sehr freuen. Alle Leistungen finden Sie hier Gesamtübersicht